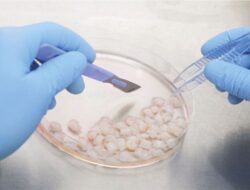
Stem Cell Mesenkimal Kini Jadi Terapi Regeneratif untuk Cedera, Disfungsional, dan Kerusakan Organ Tubuh

loading… Dunia maya diguncang dengan video viral dari seorang kreator konten asal Bali. Sang kreator…
Hiburan

Cara Menurunkan Berat Badan 6 Kg dalam Waktu 2 Minggu
loading… Menurunkan berat badan dengan cepat sering kali menjadi tantangan. Dengan diet yang tepat, penurunan…

Kate Middleton Sakit Hati dengan Komentar Kejam Meghan Markle tentang Putri Chatlotte
loading… Meghan Markle membuat komentar kejam tentang Putri Charlotte yang menyebabkan Kate Middleton sakit hati….

Pangeran William dan Kate Middleton Sepakat Putuskan Hubungan dengan Harry
loading… Pangeran William dan Kate Middleton sepakat memutuskan hubungan dengan Pangeran Harry. Pasangan suami istri…

Apakah Buah Kecubung Narkoba? Ternyata Bisa Lebih Berbahaya
loading… Informasi tentang buah kecubung yang memiliki zat aditif seperti narkoba saat ini tengah dicari…

Kaki Sering Kesemutan Apakah Itu Gejala Asam Urat?
loading… Asam urat merupakan salah satu penyakit yang kerap menyerang persendian. Gejalanya cukup beragam. Salah…

Apa Itu Fenomena Aphelion yang Terjadi Tiap Bulan Juli?
loading… Apa itu fenomena aphelion? Pertanyaan ini kerap muncul tiap kali memasuki bulan Juli. Foto…

Manfaat dan Bahaya Kecubung untuk Kesehatan, Apa Saja?
loading… Manfaat dan bahaya kecubung untuk kesehatan menarik diketahui. Tanaman tersebut belakangan ramai jadi perbincangan…

Kemenparekraf Minta SOP Destinasi Wisata Diperketat Buntut 2 Remaja Meninggal di Air Terjun
loading… Adyatama Kepariwisataan dan Ekonomi Kreatif Nia Niscaya menegaskan pentingnya penetapan peraturan di tempat wisata…
Stem Cell Mesenkimal Kini Jadi Terapi Regeneratif untuk Cedera, Disfungsional, dan Kerusakan Organ Tubuh
loading… Terapi stem cell kini tidak hanya diperuntukkan bagi kelainan darah atau kelainan sistem imun…
Tidak Ada Postingan Lagi.
Tidak ada lagi halaman untuk dimuat.

